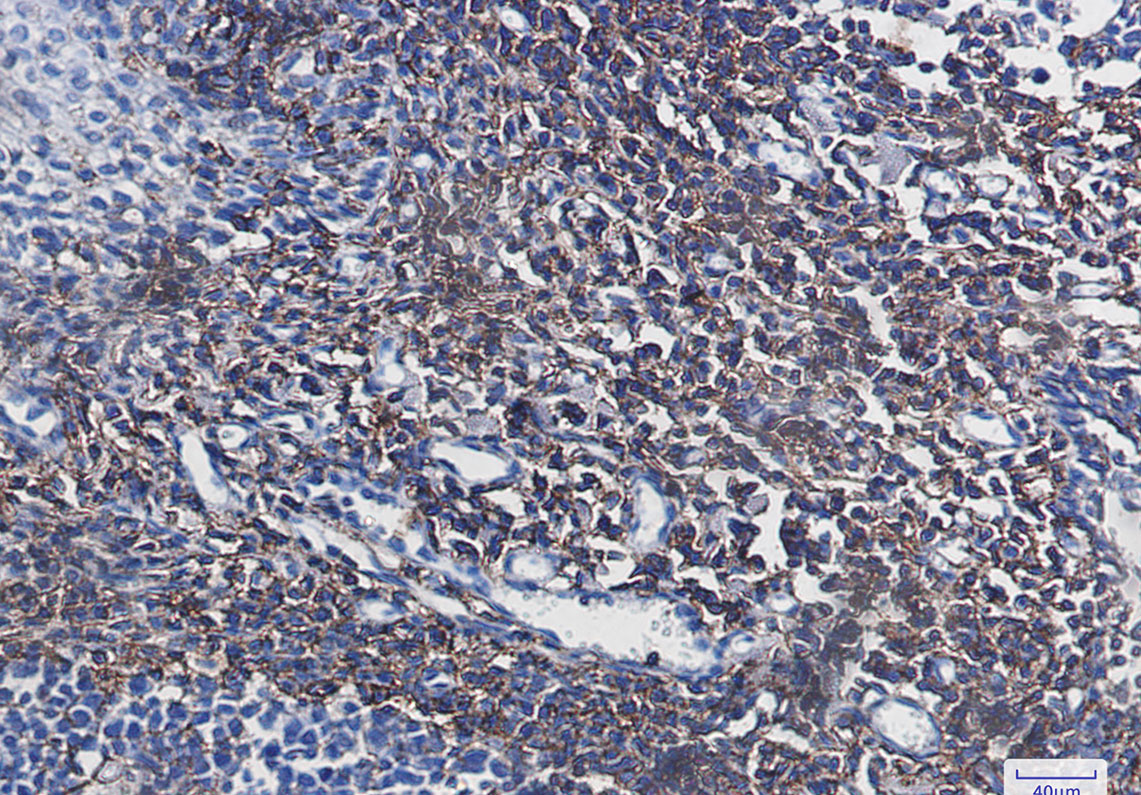

别名:CD44; LHR; MDU2; MDU3; MIC4; CD44 antigen; CDw44; Epican; Extracellular matrix receptor III; ECMR-III; GP90 lymphocyte homing/adhesion receptor; HUTCH-I; Heparan sulfate proteoglycan; Hermes antigen; Hyaluronate receptor; Phagocytic glycopr应用:WB,IHC
反应种属:Human
规格:50μl/100μl
| Description |
|---|
| Receptor for hyaluronic acid (HA). Mediates cell-cell and cell-matrix interactions through its affinity for HA, and possibly also through its affinity for other ligands such as osteopontin, collagens, and matrix metalloproteinases (MMPs). Adhesion with HA plays an important role in cell migration, tumor growth and progression. |
| Specification | |
|---|---|
| Aliases | CD44; LHR; MDU2; MDU3; MIC4; CD44 antigen; CDw44; Epican; Extracellular matrix receptor III; ECMR-III; GP90 lymphocyte homing/adhesion receptor; HUTCH-I; Heparan sulfate proteoglycan; Hermes antigen; Hyaluronate receptor; Phagocytic glycopr |
| Entrez GeneID | 960 |
| Swissprot | P16070 |
| WB Predicted band size | Calculated MW: 82 kDa; Observed MW: 82 kDa |
| Host/Isotype | Rabbit IgG |
| Storage | Store at 4°C short term. Aliquot and store at -20°C long term. Avoid freeze/thaw cycles. |
| Species Reactivity | Human |
| Immunogen | A synthetic peptide of human CD44 |
| Formulation | 50mM Tris-Glycine(pH 7.4), 0.15M NaCl, 40% Glycerol, 0.01% Sodium azide and 0.05% BSA |
| Application | |
|---|---|
| WB | 1/500-1/1000 |
| IHC | 1/50-1/100 |
![]() |
Western blot analysis of CD44 in Hela lysates using CD44 antibody. |
![]() |
Western blot analysis of CD44 in Hela lysates using CD44 antibody. |
![]() |
Immunohistochemistry analysis of paraffin-embedded Human tonsil using CD44 antibody. High-pressure and temperature Sodium Citrate pH 6.0 was used for antigen retrieval. |
本公司的所有产品仅用于科学研究或者工业应用等非医疗目的,不可用于人类或动物的临床诊断或治疗,非药用,非食用。
暂无评论
本公司的所有产品仅用于科学研究或者工业应用等非医疗目的,不可用于人类或动物的临床诊断或治疗,非药用,非食用。
中文

发表回复